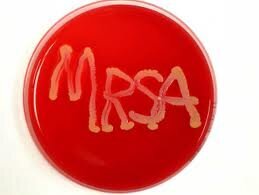

Ikke nødvendig med isolasjon
Å isolere beboere er ikke nødvendig for å forebygge smitte av MRSA på sykehjem.
Det er konklusjonen og tittelen på Petter Elstrøm sin Master of Public Health ( Å isolere beboere er ikke nødvendig for å forebygge smitte av MRSA på sykehjem) avlagt ved Nordic School of Public Health (NHV) i Gøteborg. Elstrøm jobber som seniorrådgiver ved Nasjonalt folkehelseinstitutt, Avdeling for infeksjonsovervåkning.
Isolasjon effektivt?
Meticillinresistente gule stafylokokker (MRSA) er assosiert med stor smittefare, økt risiko for komplikasjoner og død. Tidligere ble det anbefalt å isolere MRSA-positive sykehjemsbeboere på enerom. I en nasjonal MRSA-veileder fra 2009 frarådes langvarig isolering.
Er de nye anbefalingene om ikke å isolere beboere med MRSA like effektive som tidligere anbefalinger om å isolere beboere i sykehjem?
Det var spørsmålet Petter Elstrøm ønsket svar på i sin studie. Seniorrådgiveren i Nasjonalt folkehelseinstitutt ledet i sin tid arbeidet med å revidere anbefalingene til tiltak mot spredning av MRSA på helseinstitusjoner.
Målrettede tiltak
I veilederen fra 2009 er isolering erstattet med målrettede tiltak i spesielle soner og i forhold til spesielle situasjoner.
Ved MRSA skal rommet til beboeren anses som en høyrisikosone i forhold til smitte. Personalet skal bruke beskyttelsesutstyr på samme måte som ved isolering, når de steller beboeren og når de rer sengen. I tillegg skal det tas det spesielle forholdsregler ved håndtering av tekstiler, avfall inne på og fra beboerens rom og ved rengjøring av rommet.
Ellers bør beboeren kunne gå fritt rundt og være sammen med andre beboere på samme enhet eller avdeling, men personalet skal være nøye med å følge basale smittevernrutiner i all kontakt med alle beboere og ta spesielle forholdsregler i situasjoner som er forbundet med høyere risiko for smitteoverføring.
Studien viser at MRSA-tiltak anbefalt i gjeldende nasjonal MRSA-veileder fra 2009 er like effektive i forhold til å forebygge spredning av MRSA på sykehjem som tidligere anbefalt isolering
Handler også om etikk
Beslutninger som tas vedrørende smitteisolering har stor betydning for sykehjemsbeboeres helse og livskvalitet. Alle som blir isolert på enerom og som ikke får omgå andre på en normal måte vil oppleve dette som en økt belastning, spesielt om isoleringen varer over lang tid.
– Resultatene i studien viser at enkelte sykehjemsbeboere har blitt isolert på enerom over flere måneder. Å gjennomføre isolering på en effektiv måte over så lang tid vil være ekstra krevende og etisk utfordrende, ifølge Elstrøm.
Så mange som åtte av ti personer innlagt i norske sykehjem kan lide av en demenstilstand. Demens nedsetter pasientenes evne til å forstå og huske informasjon og dermed evnen til å samarbeide om smitteverntiltak. De fleste demente som også har mulighet til å bevege seg på egenhånd vil normalt ikke klare å følge et isoleringsregime. For mange beboere på sykehjem vil det for personalet være meget vanskelig eller umulig å gjennomføre isolering på en effektiv måte.
Konklusjonen i studien er at norske sykehjem ikke har noe å vinne i forhold til smittevern på å isolere beboere med MRSA. Men man kan vinne mye i forhold til økt livskvalitet og helse for den enkelte beboer om man bytter ut isolasjon med målrettede tiltak.







0 Kommentarer